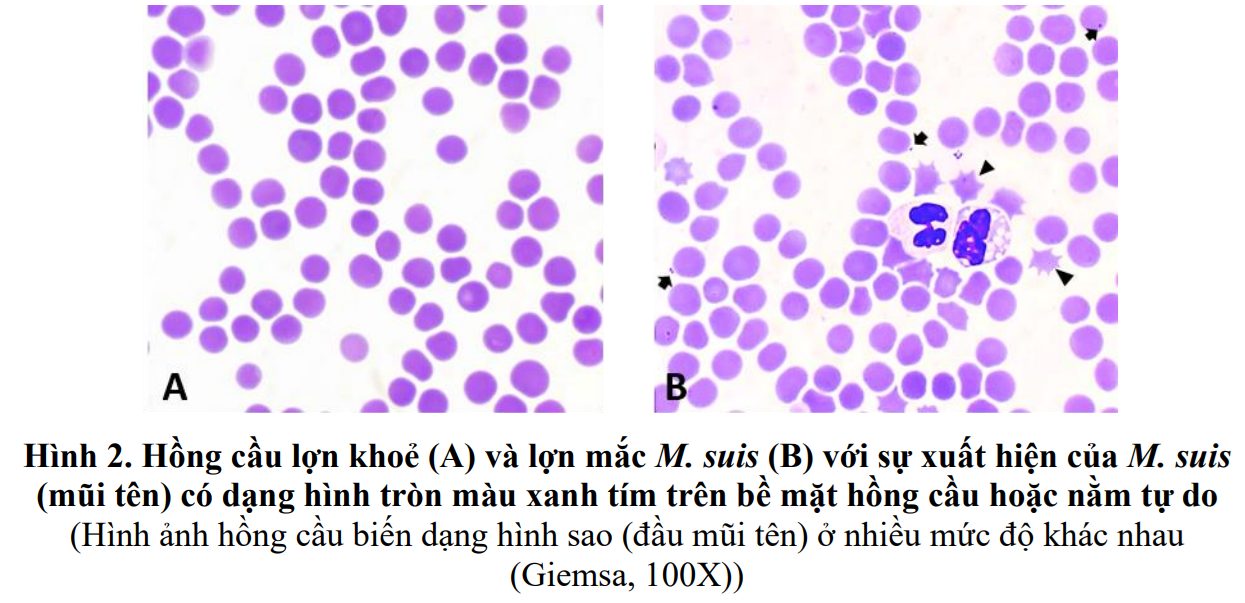

Nguyễn Phương Nhung, Phạm Hồng Trang
- Nguyên vật liệu
Ba mươi mẫu máu của lợn nái rạ giống lợn lai F1 (Yorkshire × Landrace). Trong đó sử dụng phương pháp Realtime PCR xác định 15 mẫu lợn bệnh (dương tính với M. suis) và 15 mẫu lợn khoẻ (âm tính với M. suis) được sử dụng làm đối chứng. Mỗi mẫu máu được chia đều vào 2 ống chứa EDTA và heparin, vận chuyển lạnh về Phòng Thí nghiệm trong vòng 24 giờ.
- Phương pháp nghiên cứu
2.1. Phương pháp Realtime PCR xác định sự có mặt của M. suis
DNA được tách chiết bằng kit MagMAX™ CORE Nucleic Acid Purification trên hệ thống máy tách chiết tự động KingFisher™ Duo Prime Purification của hãng Thermo Fisher Scientific, các bước tiến hành được thực hiện theo hướng dẫn của nhà sản xuất. Phản ứng Realtime PCR xác định sự có mặt của M. suis trong mẫu máu lợn sử dụng cặp mồi và đoạn dò theo Guimaraes & cs. (2011) để xác định gene 16S rRNA của M. suis.
2.2. Phương pháp nhuộm tiêu bản máu sử dụng thuốc nhuộm Giemsa
Thực hiện phiết tiêu bản máu sử dụng mẫu chống đông trong ống EDTA theo phương pháp thường quy, lựa chọn tiêu bản có các tế bào máu được dàn đều một lớp và để khô tự nhiên trước khi tiến hành nhuộm.
Phương pháp nhuộm Giemsa theo hướng dẫn của CDC (2016) được thực hiện theo quy trình (có chỉnh sửa) sau: Chuẩn bị dung dịch Giemsa 10% theo hướng dẫn của nhà sản xuất, lọc cặn (nếu có) bằng giấy lọc. Thuốc nhuộm pha để sử dụng trong ngày, không sử dụng thuốc nhuộm cũ. Cố định tiêu bản máu bằng Methanol 100% trong 1-2 phút; Để khô tự nhiên ở nhiệt độ phòng; Nhuộm tiêu bản trong dung dịch Giemsa 10% trong 10 phút, đảm bảo lượng thuốc nhuộm trong khay nhuộm phủ kín toàn bộ tiêu bản; Rửa tiêu bản dưới vòi nước lọc (qua lõi lọc), chảy tràn trên bề mặt tiêu bản trong 1-2 phút; Để khô tự nhiên ở nhiệt độ phòng. Tiêu bản được kiểm tra sử dụng kính hiển vi quang học Carl Zeiss Axio Lab.A1 (Carl Zeiss, Đức) vật kính dầu với độ phóng đại 1000 lần. Kết quả dương tính được xác định với sự có mặt của M. suis hình tròn hoặc bầu dục, bắt màu xanh tím, bám trên bề mặt hồng cầu hoặc nằm tự do trong tiêu bản. Hồng cầu có thể bị biến dạng (Hình sao) ở nhiều mức độ khác nhau.
- Kết quả
3.1. Kết quả xác định M. suis sử dụng phương pháp Realtime PCR
Căn cứ kết quả Realtime PCR để lựa chọn 15 mẫu máu lợn dương tính với M. suis và 15 mẫu máu lợn âm tính với M. suis phục vụ cho phương pháp nhuộm Giemsa.
3.2. Kết quả xác định M. suis trong mẫu máu sử dụng thuốc nhuộm Giemsa
M. suis xuất hiện trong tất cả các mẫu máu của lợn bệnh với dạng hình tròn hoặc bầu dục, nhuộm màu xanh tím. Chúng có thể bám trên bề mặt hồng cầu hoặc nằm tự do trong tiêu bản. Mật độ của M. suis có thể khác nhau giữa các tiêu bản, từ thưa thớt, rải rác cho tới tụ tập với nhau thành từng đám.
Trong các mẫu máu của lợn mắc bệnh do M. suis thể hiện cấp độ tổn thương hồng cầu khác nhau. Sự thoái hoá của hồng cầu được ghi nhận từ tất cả các mẫu bao gồm biến dạng hình sao, bắt màu nhạt với thuốc nhuộm. Bên cạnh một số mẫu ghi nhận sự xuất hiện rải rác của hồng cầu bị thoái hoá, thì một số mẫu máu ghi nhận mức độ tổn thương rất nặng với hầu hết toàn bộ hồng cầu bị biến dạng (Hình 3).
Link bài viết: 12_2025_GPTC

English